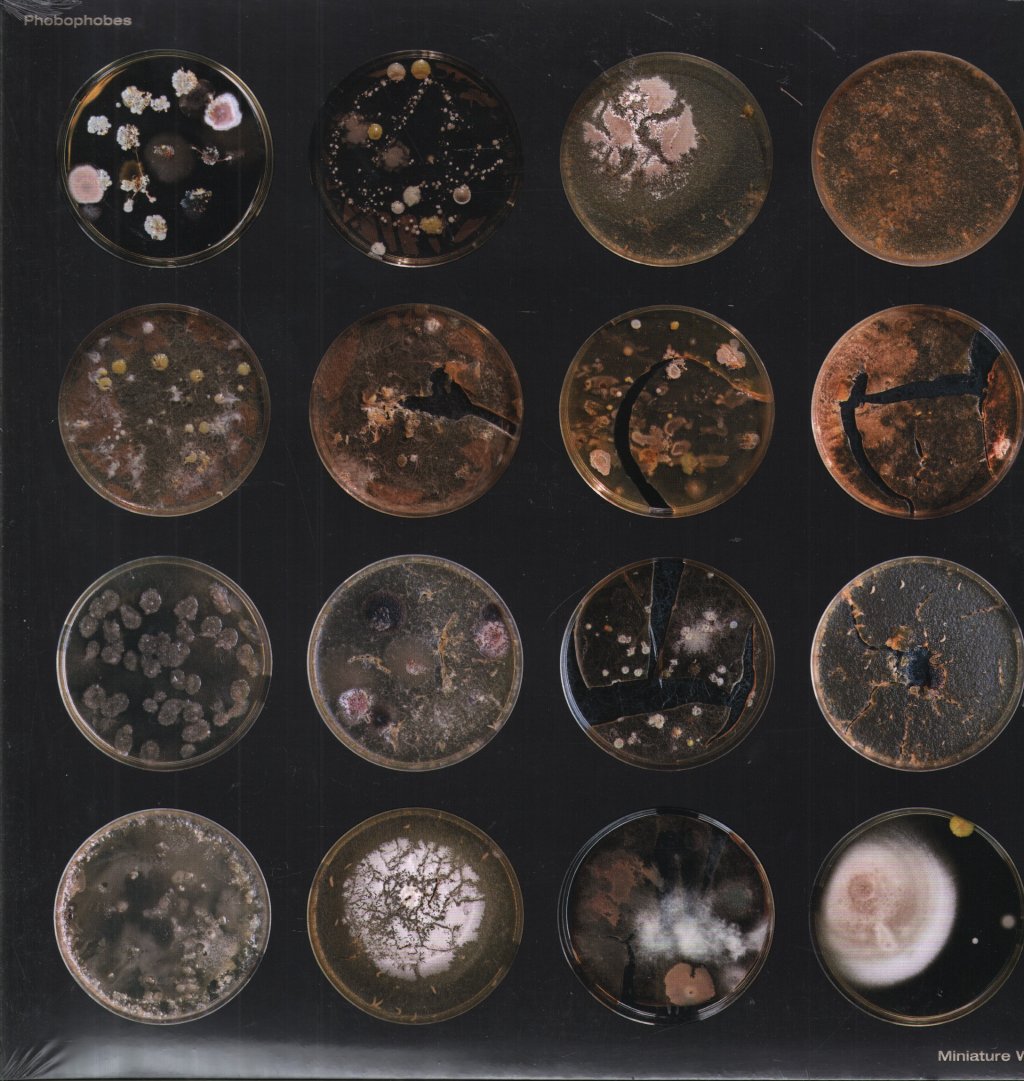
Phobophobes - Miniature World - Lp

1
/
of
2
Tax included.
In stock (ready to ship)
Couldn't load pickup availability
Artist |
TitleMiniature World |
FormatLP |
Label |
CountryUk |
Year2018 |
Genre |
GradeNEW |
Catalogue NumberROK019LPX |
Barcode5053760033929 |
Commentslimited edition 10 track clear vinyl brand new sealed |
|
Product Information
Artist
Title
Miniature World
Format
LP
Label
Country
Uk
Year
Epic
Grade
NEW
Catalogue Number
ROK019LPX
Barcode
5053760033929
Comments
limited edition 10 track clear vinyl brand new sealed
Share
SKU:
VT1727890534529
Go to product page


-
Description
-
Track List
A1. Where Is My Owner
A2. Miniature World
A3. Human Baby
A4. The Never Never
A5. Free The Naked Rambler
B1. Child Star
B2. No Flavour
B3. The Fun
B4. Mama Power
B5. Bite The Apple -
Grading Definition
View our grading system